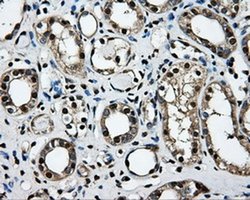
Invitrogen LOX Monoclonal Antibody (OTI9G6) 100 &mu;L; Unconjugated:Antibodies,

missing translation for 'onlineSavingsMsg'
Learn More
Learn More
Invitrogen™ LOX Monoclonal Antibody (OTI9G6)


Mouse Monoclonal Antibody
Brand: Invitrogen™ MA525033
This item is not returnable.
View return policy
Description
LOX Monoclonal Antibody for Western Blot, ICC/IF, IHC (P)
Lysyl oxidase (LOX), a copper-containing amine oxidase, belongs to a heterogeneous family of enzymes that oxidize primary amine substrates to reactive aldehydes. It plays a vital role in the formation and repair of the extra cellular matrix. As well, LOX is a multifunctional enzyme having diverse biological functions such as developmental regulation, tumor suppression, cell motility and cellular senescence. The secreted form of LOX is responsible for the invasive properties of hypoxic human cancer cells. Thus, it is essential for hypoxia-induced metastasis and is a good therapeutic target for preventing and treating metastases.
Specifications
| LOX | |
| Monoclonal | |
| 1.00 mg/mL | |
| PBS with 1% BSA, 50% glycerol and 0.02% sodium azide; pH 7.3 | |
| P28300 | |
| LOX | |
| Human recombinant protein fragment corresponding to amino acids 22-168 of LOX produced in HEK293T cell. | |
| 100 μL | |
| Primary | |
| Human | |
| Antibody | |
| IgG1 |
| Immunohistochemistry (Paraffin), Western Blot, Immunocytochemistry | |
| OTI9G6 | |
| Unconjugated | |
| LOX | |
| AI893619; cross-linking enzyme; H-rev142; LOX; Lysyl oxidase; Lysyl oxidase (an H-rev gene with its expression down-regulated in HRAS-transformed rat 208F fibroblasts); MGC105112; protein-lysine 6-oxidase; Protein-lysine 6-oxidase, long form; Protein-lysine 6-oxidase, short form; Ras excision protein; ras recision; rrg; Rrg1; TSC-160 | |
| Mouse | |
| Affinity chromatography | |
| RUO | |
| 4015 | |
| -20°C, Avoid Freeze/Thaw Cycles | |
| Liquid |
Product Content Correction
Your input is important to us. Please complete this form to provide feedback related to the content on this product.
Product Title
Spot an opportunity for improvement?Share a Content Correction